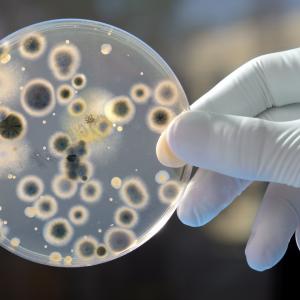

Изгорелите газове от дизеловите автомобили вредят повече на жените, отколкото на мъжете
Предварителните резултати от ограничено изследване показват, че изгорелите газове от автомобили, работещи с дизел, предизвикват повече изменения в кръвната картина, свързани с възпаления, инфекции и сърдечно-съдови заболявания, при жените, отколкото при мъжете.
Данните бяха представени в рамките на международния конгрес на Европейското дружество по респираторна медицина в Барселона, Испания.
Нелофер Мохержи, преподавател в университета на Манитоба в Уинипег, Канада посочва, че "излагането на изгорели газове от дизел действа различно на женските организми в сравнение с тези на мъжете и това може да е знак, че замърсяването на въздуха е по-опасно за жените, отколкото за мъжете".
Изследователският ѝ екип е работил по проучването заедно с учени под ръководството на Крис Карлстен от университета на Британска Колумбия във Ванкувър, Канада.
Изследването е проведено сред 10 здрави доброволци, непушачи - петима мъже и пет жени. Всеки от тях е вдишвал в продължение на четири часа филтриран въздух и по четири часа - въздух с изгорели газове от дизел с три концентрации - 20,50 и 150 микрограма фини прахови частици на куб. метър.
Учените установяват, че вдишването на дизелови изпарения води до възпаления в белите дробове и влияе на справянето на организма с инфекции на дихателните пътища.